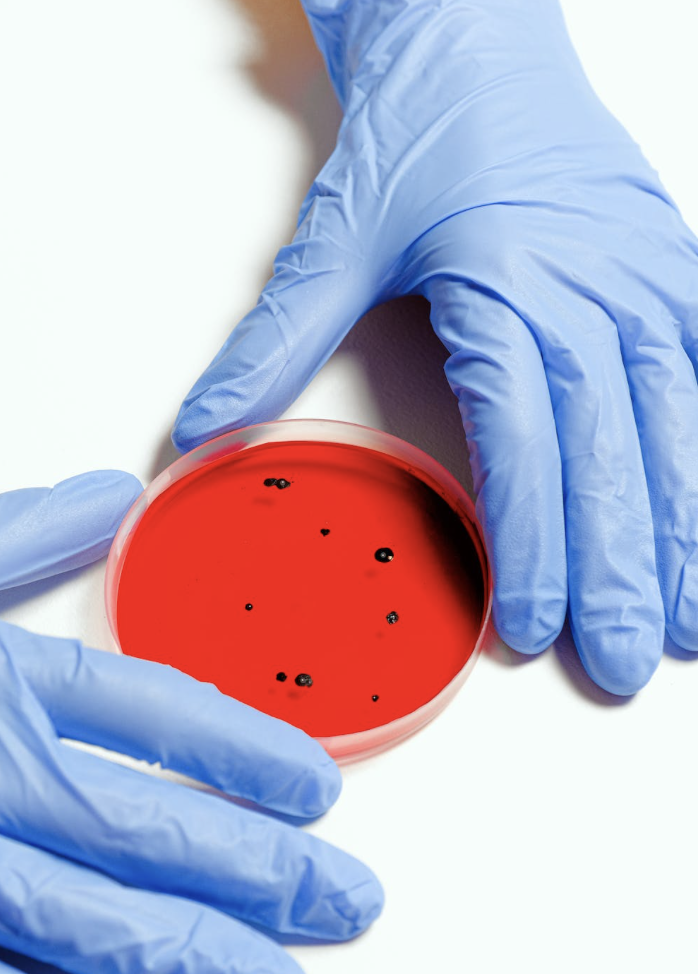
갑상선암 증상

갑상선암은 발생률이 높은 암 중 하나로, 30대 여성을 중심으로 발생하며 여성의 암 사망 원인 1위입니다.
갑상선암은 조기 발견하면 대부분 치료가 가능하므로 증상을 미리 파악하는 것이 중요합니다.
오늘은 갑상선암의 증상에 대해 알아보도록 하겠습니다.
갑상선암의 증상은 무엇인가요?
갑상선암의 증상은 크게 두 가지로 나눌 수 있습니다.
첫째, 갑상선의 크기 변화로 인한 증상이 있습니다.
갑상선의 크기가 커지면 목의 앞쪽이 불편해지고, 목이 뻐근하거나 눌리는 듯한 느낌이 들며, 목의 아래쪽에 압박감이 느껴질 수 있습니다.
둘째, 갑상선 호르몬의 분비량 변화로 인한 증상이 있습니다.
갑상선 호르몬의 분비량이 증가하면 땀이 많이 나고, 손발이 떨리며, 심장이 빨리 뛰고, 불안감이나 불면증 등의 증상이 나타날 수 있습니다.
반대로 갑상선 호르몬의 분비량이 감소하면, 피로감, 무기력감, 기억력 저하, 냉감증 등의 증상이 나타날 수 있습니다.

갑상선암은 어떻게 진단하나요?
갑상선암은 주로 초음파 검사, 혈액 검사, 조직 검사 등을 통해 진단됩니다.
초음파 검사는 갑상선의 크기와 결절 등을 확인할 수 있으며, 혈액 검사는 갑상선 호르몬의 분비량을 측정하여 갑상선 기능 이상 여부를 확인할 수 있습니다.
조직 검사는 갑상선 결절이 악성인지 확인하기 위해 시행되며, 갑상선암 진단의 가장 확실한 방법입니다.

갑상선암의 치료 방법은 무엇인가요?
갑상선암의 치료 방법은 갑상선 전적출술, 방사선 치료, 항암제 치료 등이 있습니다.
갑상선 전적출술은 갑상선 전체를 제거하는 수술로, 갑상선암의 종류와 진행 정도에 따라 수술 범위가 달라집니다.
방사선 치료는 수술 후 잔존 암세포를 제거하기 위해 시행되며, 항암제 치료는 수술 후 전신 치료를 위해 시행됩니다.
갑상선암의 치료 방법은 갑상선암의 종류와 진행 정도에 따라 달라지므로, 갑상선암이 의심될 경우 적극적인 검사와 치료가 필요합니다.
갑상선암은 조기 발견과 적극적인 치료로 대부분 치료가 가능합니다.
갑상선암의 증상이 있다면, 빠른 시일 내에 전문의를 찾아 검사를 받아보세요.
갑상선암에 대한 빠른 대처는 치료의 성공률을 높이는 데 큰 도움이 됩니다.
'유용한 정보' 카테고리의 다른 글
| 담보대출금리 비교할때 중요한 팁(+은행연합회 소비자포털 사이트) (0) | 2023.04.20 |
|---|---|
| 초미세먼지 폐암 유발 원리 (0) | 2023.04.17 |
| 안구건조증 원인 및 증상, 예방및 치료방법 (0) | 2023.04.08 |